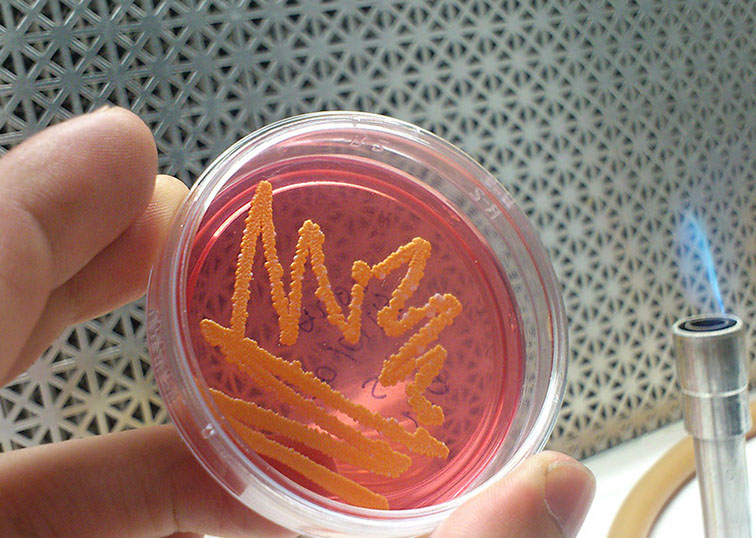

CONVOCATORIA DE INGRESO 2026-1
--
Acerca de
La Universidad Michoacana de San Nicolás de Hidalgo ha implementado un Programa de Maestría Institucional en el área de las Ciencias Biológicas (PIMCB), en el cual participan investigadores de cinco dependencias:
- Facultad de Químico Farmacobiología
- Facultad de Biología
- Facultad de Medicina Veterinaria y Zootecnia
- Facultad de Agrobiología
- Instituto de Investigaciones Agropecuarias y Forestales
En el PIMCB los profesores investigadores de las cinco dependencias, se agrupan en ocho áreas temáticas:
- Biotecnología Alimentaria
- Biología Evolutiva
- Biotecnología Pecuaria
- Ecología y Conservación
- Fisiología y Genética Vegetal
- Interacción Planta-Microorganismo-Insecto
- Microbiología Celular y Genética Molecular
- Producción y Salud Animal

Facultad de Químico Farmacobiología

Facultad de Agrobiología "Presidente Juárez"
Facultad de Medicina Veterinaria y Zootecnia
Instituto de Investigaciones Agropecuarias y Forestales
Facultad de Biología
CONVOCATORIA DE INGRESO 2026-1
La Universidad Michoacana de San Nicolás de Hidalgo convoca a los interesados para ingresar al Programa Institucional de Maestría en Ciencias Biológicas (PIMCB) en las siguientes áreas temáticas:
- Biotecnología Alimentaria
- Biotecnología Pecuaria
- Ecología y Conservación
- Fisiología y Genética Vegetal
- Interacción Planta-Microorganismo-Insecto
- Microbiología Celular y Genética Molecular
- Producción y Salud Animal
- Biología Evolutiva
REQUISITOS DE ADMISIÓN
ASPIRANTES NACIONALES
- Poseer el grado de Licenciatura en alguna disciplina de las Ciencias Biológicas y tener un promedio mínimo de 8.0 (ocho punto cero o equivalente), de acuerdo con la normatividad del programa. El aspirante deberá estar titulado del nivel licenciatura previamente al cierre de la convocatoria.
- El aspirante deberá presentar:
- Documentos de identificación personal: acta de nacimiento reciente, copia de credencial INE vigente, CURP reciente y constancia de Registro Federal de Contribuyentes RFC SAT.
- Certificado oficial de calificaciones de licenciatura con promedio (no memorándum), cédula profesional (o su trámite correspondiente) y título profesional o acta de examen (si se presenta acta de examen, deberá incluir constancia de título en trámite).
- Documento probatorio de registro de ingreso al PIMCB en la página oficial de la Convocatoria General de ingreso a los Posgrados de la UMSNH (https://siiaapp.siia.umich.mx/aspi/comienzoposgrado).
- Anteproyecto de tesis en un documento de 5 cuartillas, con la portada avalada con la firma autógrafa del director de tesis (quien debe ser miembro activo del Claustro Académico del Programa).
- Carta del director de tesis (y en su caso del codirector), en la que se indique el interés por incorporar al estudiante a un proyecto de investigación, la existencia de financiamiento, infraestructura y recursos suficientes para el desarrollo de su investigación. Currículum en extenso del aspirante con documentos probatorios y un resumen curricular del director (y en su caso del codirector).
- Carta compromiso de dedicación a tiempo completo del aspirante. (Formato disponible en https://www.pimcb.umich.mx).
- Carta de motivos del aspirante para ingresar al Programa en formato libre, dirigida al Coordinador General del Programa.
- Tres cartas de recomendación en sobre cerrado y en el formato disponible en https://www.pimcb.umich.mx (no deberán ser emitidas por el director, ni codirector del postulante).
- Acreditar el examen de inglés TOEFL con un mínimo de 350 puntos. El documento original que se presente deberá estar vigente al momento de la entrega. Informes sobre fechas de examen: Departamento de Idiomas de la Universidad Michoacana de San Nicolás de Hidalgo. Tel. 3223500 ext. 3114. (La vigencia del documento presentado es de un año a partir de la fecha de su expedición).
- Presentar y aprobar el examen CENEVAL-EXANI III con un puntaje global mínimo de 950 puntos. El documento original que se presente debe estar vigente al momento de entrega. Informes con la maestra Ma. Del Carmen Arias Valencia, en el Edificio de Posgrado de la Universidad Michoacana de San Nicolás de Hidalgo. Tel. 3223500 ext. 4157, correo electrónico del.arias@umich.mx. También puede consultar las fechas del examen nacional directamente en la página de CENEVAL www.ceneval.edu.mx/exani-iii
- Presentar y aprobar un curso propedéutico presencial con un mínimo de 8.0 (ocho punto cero) a realizarse tentativamente del 12 al 16 de enero de 2026.
- Presentar y aprobar una entrevista presencial con el Comité de Selección, con un mínimo de 8.0 (ocho punto cero). La fecha específica de la entrevista se dará a conocer una vez que el aspirante haya cursado y aprobado el curso propedéutico. Las entrevistas se harán tentativamente durante la semana del 19 al 23 de enero de 2026. Solamente los aspirantes que cumplan con todos los requisitos tendrán derecho a presentar entrevista.
- La recepción de todos los documentos mencionados será desde la publicación de la presente convocatoria, hasta el 05 de diciembre de 2025. Deberán hacerse llegar en formato digital a las direcciones electrónicas del coordinador del área temática y del programa (mae.ciencias.biologicas@umich.mx). De igual forma, deberán entregarse de forma física a través de los Coordinadores de cada una de las Áreas Temáticas. Los documentos digitales deberán identificarse de manera individual como se describe en la página del programa https://www.pimcb.umich.mx).
- No se aceptarán expedientes incompletos y no existirán prórrogas de ningún tipo.
ASPIRANTES EXTRANJEROS
Las normas complementarias del PIMCB indican que los estudiantes extranjeros interesados en ingresar al programa deberán cumplir los puntos aplicables anteriores, además de los siguientes requisitos:
- Las calificaciones y el promedio obtenido en el grado anterior (licenciatura) deberán presentarse mediante documentos oficiales certificados emitidos por la institución académica que otorga el grado, y su correspondiente aval oficial de equivalencias, si es que se requiere.
- Presentar el examen EXANI III o equivalente (como el Graduate Record Examination o GRE).
- Los aspirantes extranjeros radicados en México, deberán presentar y aprobar el curso propedéutico presencial mencionado previamente con un mínimo de 8.0 (ocho punto cero).
- Los aspirantes extranjeros no radicados en México, estarán exentos de asistir al curso propedéutico. Las entrevistas para estos candidatos se harán en línea.
Para la aclaración de dudas y trámites, dirigirse directamente con los Coordinadores de las Áreas Temáticas del PIMCB.
- Los exámenes TOEFL y CENEVAL-EXANI III podrán presentarse de forma virtual o presencial.
- El PIMCB es un programa Nivel I, para el que las becas son otorgadas por la Secretaría de Ciencia, Humanidades, Tecnología e Innovación (SECIHTI); las becas se asignan en orden de prioridad.
- Los asuntos no contemplados en la presente convocatoria serán resueltos por el Consejo Académico del Programa Institucional de Maestría en Ciencias Biológicas, y sus resoluciones serán inapelables.
- La publicación de resultados de los estudiantes aceptados en orden de prioridad será el 30 de enero de 2026, a través de la dirección electrónica de los aspirantes. Los cursos iniciarán el 02 de marzo de 2026.
Información sobre del programa:
La información sobre el Programa Institucional de Maestría en Ciencias Biológicas puede ser consultada en los siguientes sitios: https://www.pimcb.umich.mx/ y/o https://www.facebook.com/PIMCB.UMSNH
AVISO CONVOCATORIA
INGRESO 2026-1
COORDINADORES DE ÁREAS TEMÁTICAS
Biología Evolutiva
Dra. Clementina González Zaragoza
clementina.gonzalez@umich.mx
4431383584
Biotecnología Alimentaria
Dr. Rosalio Mercado Camargo
rosalio.mercado@umich.mx
4431304770
Biotecnología pecuaria
Dr. Rodolfo López Gomez
rodolfo.lopez.gomez@umich.mx
4432198694
Ecología y conservación
Dr. Alejandro Hiram Marín Leyva
alejandro.marin@umich.mx
4431648430
Fisiología y Genética Vegetal
Dr. Héctor Guillén Andrade
hector.guillen@umich.mx
4521057570
Interacción planta-microorganismo- insecto
Dra. Ana Mabel Martínez Castillo
ana.martinez@umich.mx
443 123 8644
Microbiologia Celular y Genética Molecular
Dr. Alejandro Bravo Patiño
alejandro.bravo@umich.mx
4431860263
Producción y Salud Animal
Dr. Daniel Val Arreola
dval@umich.mx
4432466678
Área Temática Ecología y Conservación
| Materia | Horario | Profesor | Contacto |
|---|---|---|---|
| Sistemas de información geográfica | Jueves de 8:00-12:00 horas | Dr. Juan Manuel Ortega Rodríguez | jortega@umich.mx |
| Interacciones suelo-planta-microorganismos | POR DEFINIR | Dr. Héctor Javier Anselmo Villegas Moreno | vmoreno@umich.mx |
| Técnicas ecofisiológicas aplicadas a la restauración de ecosistemas degradados | Martes de 14:00-18:00 horas | Dra. Mariela Gómez Romero | mariela.gomez@umich.mx |
| Comunicación científica | Martes y jueves de 16:00-18:00 horas | Dr. José Fernando Villaseñor Gómez | jose.fernando.gomez@umich.mx |
| Ecología de la Restauración | Martes 16:00-19:00 | Dr. Arnulfo Blanco García | arnulfo.blanco@umich.mx |
| Métodos Multivariados | Miércoles 10:00 a 14:00 horas | Dr. Javier Ponce Saaveedra | javier.ponce@umich.mx |
| Paleobiología y Tafonomía de mamíferos fósiles | Jueves de 16:00-20:00 | Dr. Alejandro Hiram | alejandro.marin@umich.mx |
| Ecología de Paisajes Antropizados | Martes de 16:00- 19:00 | Dra. Yvonne Herrerías Diego | yvonne.herrerias@umich.mx |
| Ictiología | Dra. Martina Medina Nava | martina.medina@umich.mx |
Área Temática Biología Evolutiva
| Materia | Horario | Profesor | Contacto |
|---|---|---|---|
| Ecología química de la interacción planta-animal | Martes y jueves de 10:00-12:00 | Dra. Yesenia Martínez Díaz | yesenia.diaz@umich.mx |
| Filogenias en Ecología y Conservación | Horario flexible | Dra. Clementina González Zaragoza | clementina.gonzalez@umich.mx |
| Ecología Evolución y Comportamiento | Lunes 10:00-14:00 | Dr. Luis Felipe Mendoza Cuenca | lfmendoza@umich.mx |
Área Temática Genética y fisiología vegetal
| Materia | Horario | Profesor | Contacto |
|---|---|---|---|
| Cultivo in vitro de orquídeas: propagación y mejoramiento genético | Horario por definir | Dra. Martha E. Pedraza Santos | martha.elena.pedraza@umich.mx |
| Manejo de recursos genéticos forestales | Horario por definir | Dr. Cuauhtémoc Sáenz Romero | csaenz@umich.mx |
| Modelamiento de nicho ecológico y áreas de distribución geográfica | Horario por definir | Dr. Ulises Manzanilla Quiñones | ulises.manzanilla@umich.mx |
PROGRAMA ACADÉMICO
El Programa de Maestría agrupa investigadores de las dependencias participantes en seis Áreas Temáticas con la finalidad de generar recursos humanos a nivel de Maestría con conocimientos teóricos y prácticos que les permitan participar en el desarrollo de la ciencia y tecnología en el campo de las Ciencias Biológicas y que tengan un impacto científico y tecnológico en los ámbitos regional y nacional.
El Estado de Michoacán es una zona productora de recursos naturales, agrícolas y pecuarios. La diversidad de su fauna y su flora la hace una zona rica en los recursos antes mencionados. Sin embargo, éstos no han sido aprovechados en su totalidad en forma adecuada, debido a la falta de desarrollo tecnológico y a un programa de investigación dirigido y apropiado en la región mencionada.
OBJETIVO GENERAL
Formar recursos humanos con un nivel de conocimientos y de experiencia científica en ciencias biológicas, que les permita realizar investigación original y continuar con éxito su formación académica en un programa de doctorado y/o insertarse con éxito en el sector público o privado.
OBJETIVOS PARTICULARES
Formar recursos humanos con los conocimientos y técnicas suficientes para:
- Resolver problemas de índole biológica mediante el empleo de herramientas científicas.
- Proponer y desarrollar proyectos de investigación en el área biológica.
- Generar conocimiento innovador en el área biológica.
- Continuar con éxito sus estudios de doctorado, en el área de las ciencias biológicas.
- Insertarse exitosamente en el ámbito de la producción en el sector público y en el privado así como en el académico y de investigación.
PERFIL DE INGRESO
Para ingresar al programa Institucional de Maestría en Ciencias Biológicas, el aspirante deberá poseer conocimientos académicos básicos sobre el área de las ciencias biológicas en general y medianamente avanzados sobre su proyecto de investigación en particular, así como destreza para el manejo de herramientas informáticas. Además deberá poseer conocimientos suficientes del idioma inglés para abordar la lectura y comprensión de artículos científicos sobre su tema de investigación.
PERFIL DE EGRESO
El egresado del Programa Institucional de Maestría en Ciencias Biológicas manejará con profundidad y actualización los fundamentos científicos en el área de las ciencias biológicas.
- El egresado estará capacitado en la aplicación del método científico en el área de las ciencias biológicas (identificación del problema, planteamiento de hipótesis y objetivos, estrategia metodológica, análisis de resultados y redacción de tesis).
- El egresado será capaz de participar en la propuesta y desarrollo de proyectos de investigación en el área biológica.
- El egresado tendrá la posibilidad de incorporarse a programas de Doctorado en Ciencias en el área biológica, en particular al Programa Institucional de Doctorado en Ciencias Biológicas de la U.M.S.N.H.
- El egresado será capaz de integrarse en los sectores productivos (agrícola, pesquero, acuícola, pecuario, alimentario, y ambiental), académico y de investigación.
EFICIENCIA TERMINAL EN 2.5 AÑOS
PORCENTAJE TOTAL DE GRADUADOS
PORCENTAJE DE GRADUADOS EN TIEMPO
Áreas temáticas
En el PIMCB los profesores investigadores de las 5 dependencias, se agrupan en ocho áreas temáticas:
Biotecnología Pecuaria
Interacción Planta-Microorganismo-Insecto
Fisiología y Genética Vegetal
Ecología y Conservación
Producción y Salud Animal
Microbiología Celular y Genética Molecular
Biotecnología Alimentaria
Biología Evolutiva
Núcleo académico básico
Profesores Externos del NAB

Laboratorio de Biología Acuática, Facultad de Biología, Universidad Michoacana de San Nicolás de Hidalgo, Morelia, Michoacán, México.
Coordinación académica
Instancia académico administrativa coordinadora de las actividades académicas del PIMCB, integrado por el Coordinador General y los Coordinadores de Área Temática.
CONSEJO ACADÉMICO
Coordinadora General del Programa
Dra. Martha Elena Pedraza Santos
jef.div.posg.fab@umich.mx
Jefe de División de Estudios de Posgrado de la Facultad de Químico Farmacobiología
Dr. Rafael Zamora Vega
jef.div.posg.fqfb@umich.mx
Instituto de Investigaciones Agropecuarias y Forestales
Dr. Alejandro Martínez Palacios
alejandro.palacios@umich.mx
Jefe de División de Estudios de Posgrado de la Facultad de Medicina Veterinaria y Zootecnia
Dra. Rosa Elvira Nuñez Anita
rosa.anita@umich.mx
Jefe de División de Estudios de Posgrado de la Facultad de Biología
Dr. José Fernando Villaseñor Gómez
jef.div.posg.fb@umich.mx
COORDINADORES DE ÁREAS TEMÁTICAS
Biología Evolutiva
Dra. Clementina González Zaragoza
clementina.gonzalez@umich.mx
4431383584
Biotecnología Alimentaria
Dr. Rosalio Mercado Camargo
rosalio.mercado@umich.mx
4431304770
Biotecnología pecuaria
Dr. Rodolfo López Gómez
rodolfo.lopez.gomez@umich.mx
4432198694
Ecología y conservación
Dr. Alejandro Hiram Marín Leyva
alejandro.marin@umich.mx
4431648430
Fisiología y Genética Vegetal
Dr. Héctor Guillén Andrade
hector.guillen@umich.mx
4521057570
Interacción planta-microorganismo- insecto
Dra. Ana Mabel Martínez Castillo
ana.martinez@umich.mx
4431238644
Microbiologia Celular y Genética Molecular
Dr. Alejandro Bravo Patiño
alejandro.bravo@umich.mx
4431860263
Producción y Salud Animal
Dr. Daniel Val Arreola
dval@umich.mx
4432466678
FORMATOS
Formatos de ingreso 2021
Formato de registro
Formato de carta compromiso PIMCB
Formato de carta de recomendación
Formatos de Seminario de Investigación
Seminario de Investigación I
Seminario de Investigación II
Seminario de Investigación III
Seminario de Investigación IV
Oficios
Oficio de solicitud del Comité Sinodal
Nos interesa conocer tu opinión